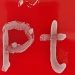
Investigadores impulsan el uso de metales para tratar infecciones

Cuando Equinox Partners Investment Management adoptó una política de votación estricta contra los directores de la industria que han trabajado durante dos o más años pero que han invertido menos de dos años de los honorarios de los directores en el capital subyacente, tomó una posición a favor del valor para los accionistas que rara vez se ve en el espacio junior.
El fondo de cobertura con sede en Nueva York, con más de $700 millones en activos totales bajo administración con más de la mitad en mineros junior de oro y plata, anunció su nueva administración de inversiones política hacia los directores de empresas públicas el mes pasado.
Establece «un límite inferior claro para la propiedad de acciones de los directores», según el director de inversiones Sean Fieler.
Dijo que Equinox Partners tiene la intención de hacer retroceder la creciente indiferencia de las juntas directivas hacia la propiedad de acciones de los directores no ejecutivos y la decisión de algunas empresas de prohibir que los directores no ejecutivos posean acciones por completo.
“Hemos visto un énfasis preocupante en la alineación financiera entre las empresas mineras internacionales”, dijo Fieler en una entrevista.
El ejecutivo subrayó que la empresa no actúa como un inversionista activista, sino que vela por sus intereses como inversionista de valor a largo plazo.
Equinox ha implementado una política rígida de no votar por directores, incluso si se postulan en una elección sin oposición.
“Si esos directores no poseen al menos un límite muy inferior de acciones, que determinamos que son dos años de la compensación de su directorio si sirvieron durante dos años o más, y creemos que eso es increíblemente generoso, probablemente demasiado bajo, En el límite inferior, tienen una visión del papel de un director realmente diferente a la nuestra”, dijo.
“La política obtiene ese 10% de los peores actores”.
Al ascender a las personas que no poseen acciones y es poco probable que adquieran un interés financiero significativo en la empresa que supervisan, la junta está incorporando colegas que tenderán a priorizar la «colegialidad» y la «reputación» por encima de los intereses financieros de la empresa, particularmente en los más jóvenes. espacio dorado, argumenta el ejecutivo.
Salas de juntas 'Club'
Fieler dijo que había sido testigo de la disminución de los niveles de propiedad interna en GDX en una franja de empresas en los últimos siete años.
“Ves una caída significativa en la propiedad interna, y realmente vemos un número creciente de directorios que tratan un puesto de director como un puesto realmente tecnocrático para llenar en lugar de una persona técnicamente competente que se alineará con los accionistas, y creemos que eso es problemático, » él dijo.
Fieler señala la adquisición propuesta de Gold Fields (NYSE: GFI; JSE: GFI) de Yamana Gold (TSX: YRI; NYSE: AUY) como una “arruga particularmente interesante en todo este problema”.
El contexto del acuerdo de Yamana es un excelente ejemplo de cómo cuando uno analiza la lista de razones para buscar una fusión, la valoración no está entre ellas, argumenta.
Y si uno tiene una mayoría en la junta que no está alineada con los accionistas, significa problemas para los inversores.
Desde que la minera con sede en Johannesburgo se acercó a su objetivo, los accionistas han criticado la fusión de acciones propuesta, argumentando que el enfoque amistoso no garantiza el crecimiento y la rentabilidad.
Fieler señala que el caso de Gold Fields es peculiar en su política, afirmando que los directores no ejecutivos no deberían estar alineados con los accionistas para que puedan representar mejor a todas las partes interesadas.
“No es en gran medida algo aleatorio lo que está sucediendo en ese caso, es una especie de resultado natural de una política potencial para desenredar a los propietarios de la empresa de la junta. Es más de lo que se ha hecho normalmente en la naturaleza 'clubby' de las salas de juntas”, dijo Fieler.
“Ese parece un ejemplo particularmente extremo, pero algo que creemos que está profundamente equivocado”.
Si bien no existe una ley que prohíba tener una sala de juntas 'clubby', según Fieler, las juntas y los presidentes de las juntas no quieren disidentes en las salas de juntas. Hace más difícil gobernar esas empresas.
“Pero como regla general, en el espacio de la minería junior, no vemos un esfuerzo por parte de los expertos para invitar a los accionistas al directorio o a los accionistas sustanciales bajo el directorio”, dijo Fieler.
“Esa no es la norma. Y debido a eso, realmente puede haber intereses divergentes entre los accionistas, incluso entre accionistas sustanciales y personas con información privilegiada en estas empresas. Y luego eso conduce a varios comportamientos poco atractivos desde la perspectiva de los accionistas.”